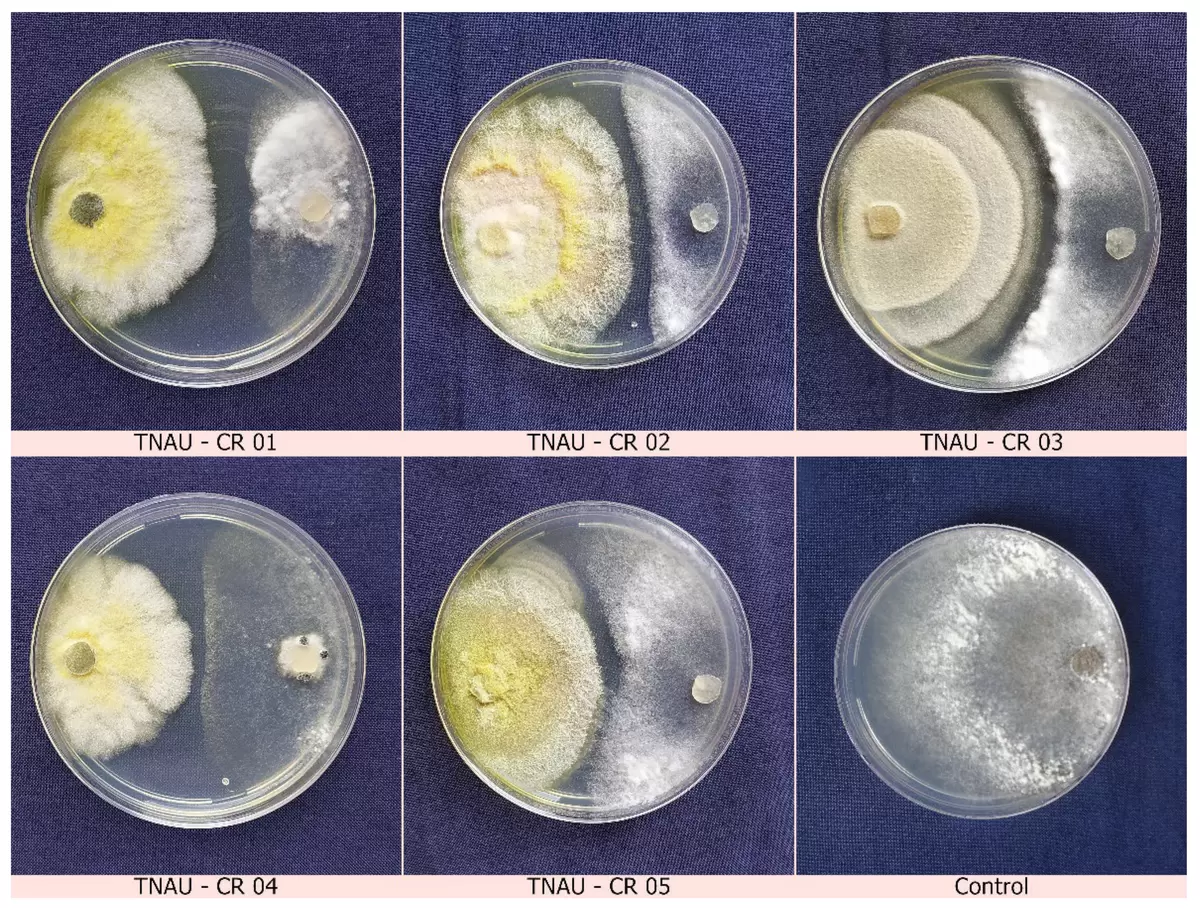

Клоностахис: универсальный защитник растений
Клоностахис, также известный как Clonostachys rosea, представляет собой мощный почвенный гриб, который активно применяется для биологического контроля. Он успешно справляется с такими патогенами, как фузариоз, ботритис и нематоды, а также белокрылка. Этот гриб не только защищает растения, но и способствует их росту, улучшая развитие корневой системы и повышая усвоение питательных веществ. В результате, грибы помогают повышать устойчивость к болезням и неблагоприятным условиям окружающей среды.
Триходерма: мощное биоудобрение
Триходерма — это гриб, популярный садоводам благодаря своим неоспоримым достоинствам. Он действует как биостимулятор, колонизируя корни растений, что улучшает усвоение питательных веществ, особенно фосфора. Этот гриб не только борется с почвенными патогенами, но и устойчив к стрессам, что делает его незаменимым помощником для садоводов. Триходерму можно использовать различными способами, включая обработку семян и полив почвы.
Клоностахис и Триходерма в одном подходе
При выборе между клоностахисом и триходермой важно понимать, что оба гриба имеют свои уникальные свойства:
- Эффективность против болезней: Клоностахис проявляет высокую активность в борьбе с Botrytis и Fusarium, действуя как некротрофный микопаразит. В то же время, Триходерма отлично конкурирует с корневыми гнилями и эффективно борется с возбудителями, оставшимися в почве.
- Защита от вредителей: Клоностахис значительно превосходит Триходерму в борьбе с вредителями, такими как белокрылка и щитовка. Его способность вызывать до 75% смертности у вредителей делает его надежным союзником.
Клоностахис также отмечается тем, что увеличивает массу корней и способствует росту растений, тогда как Триходерма акцентирует внимание на внешней микоризе. Несмотря на то, что они могут проявлять антагонистические свойства, на практике их совместное применение обеспечивает синергетический эффект, позволяя использовать преимущества обоих видов.
Заботьтесь о здоровье ваших растений, сочетая лучшие природные решения для эффективной защиты и роста!






























